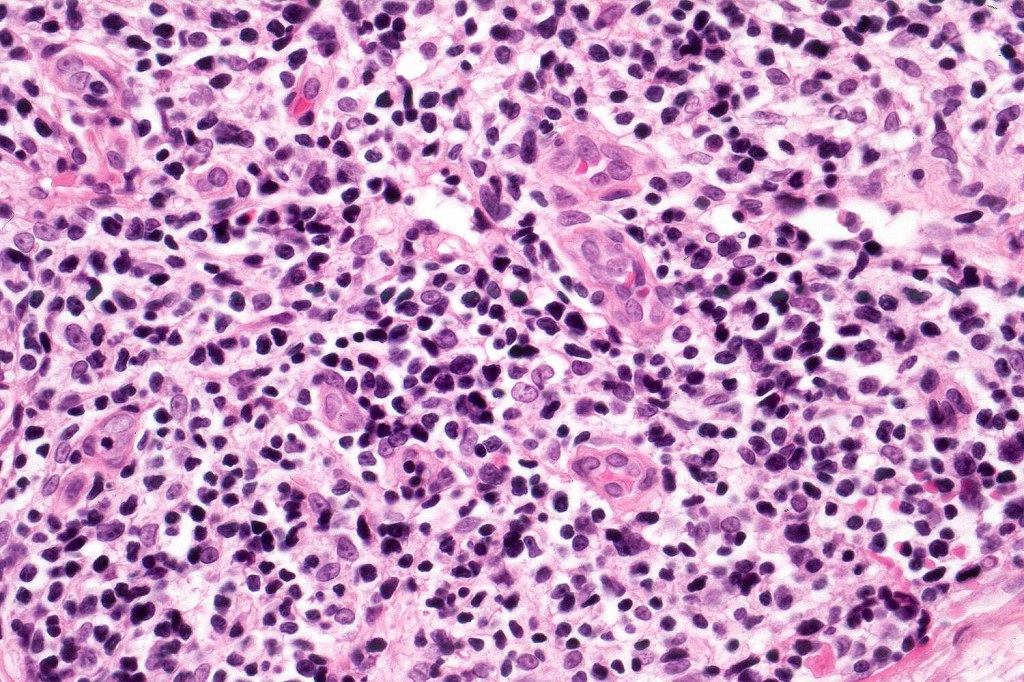
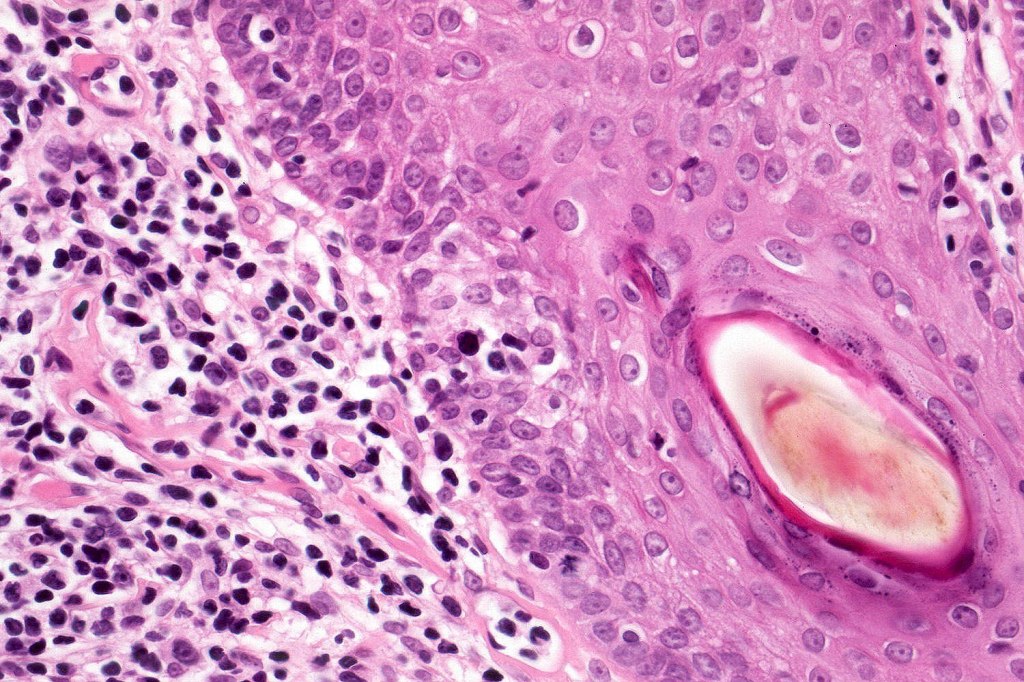
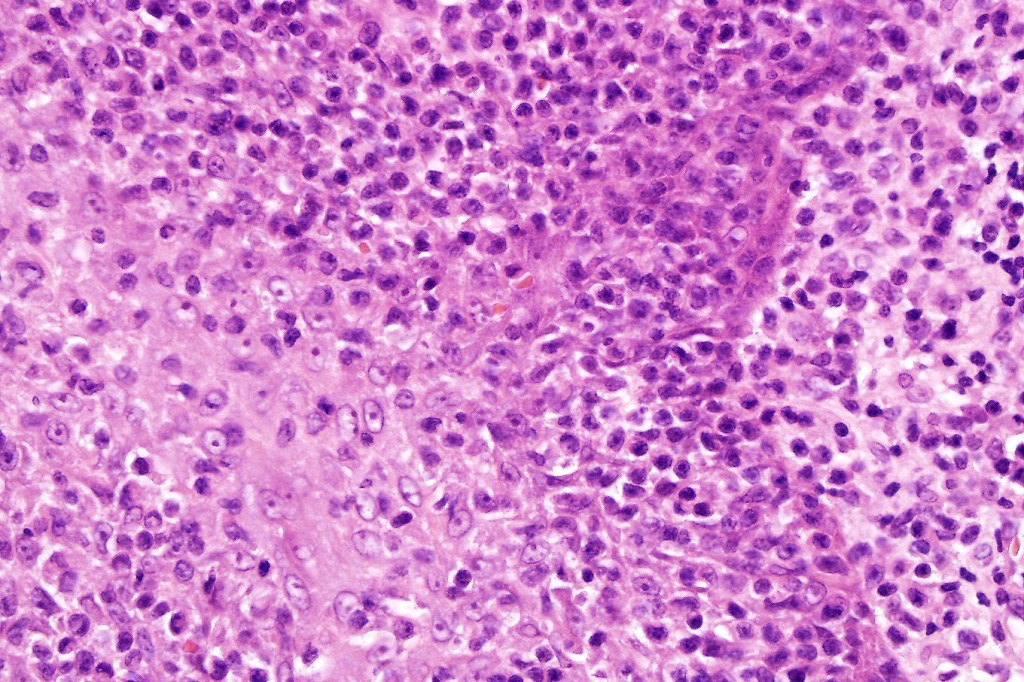
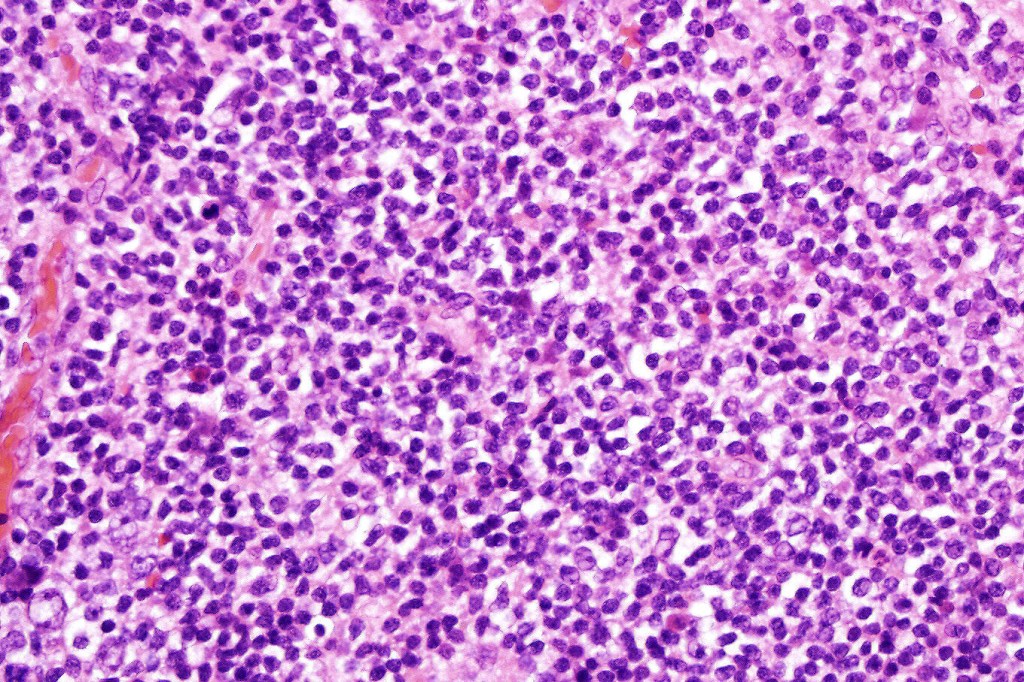
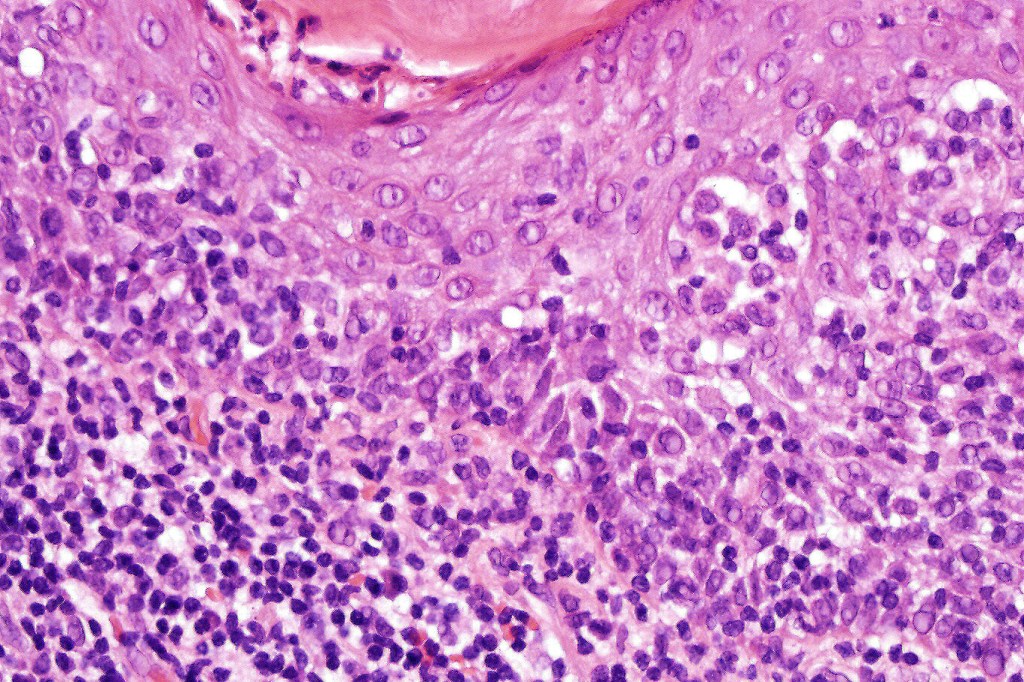
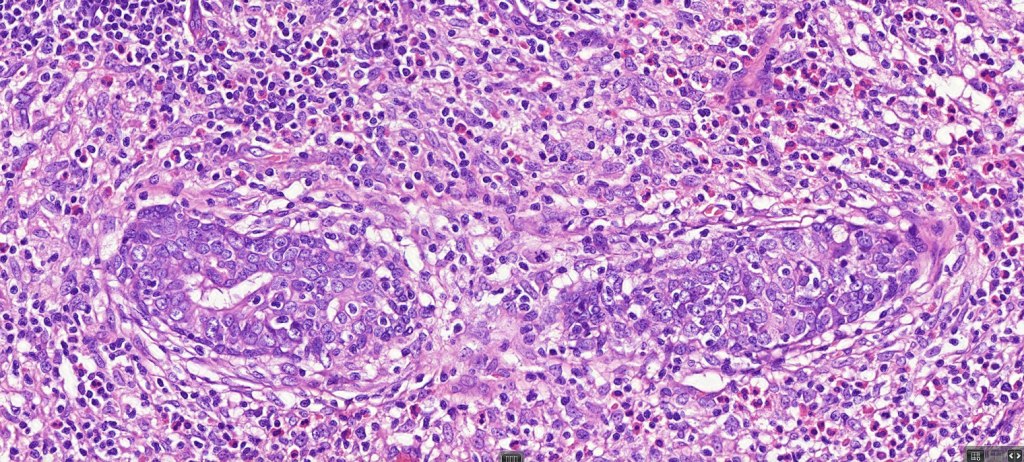
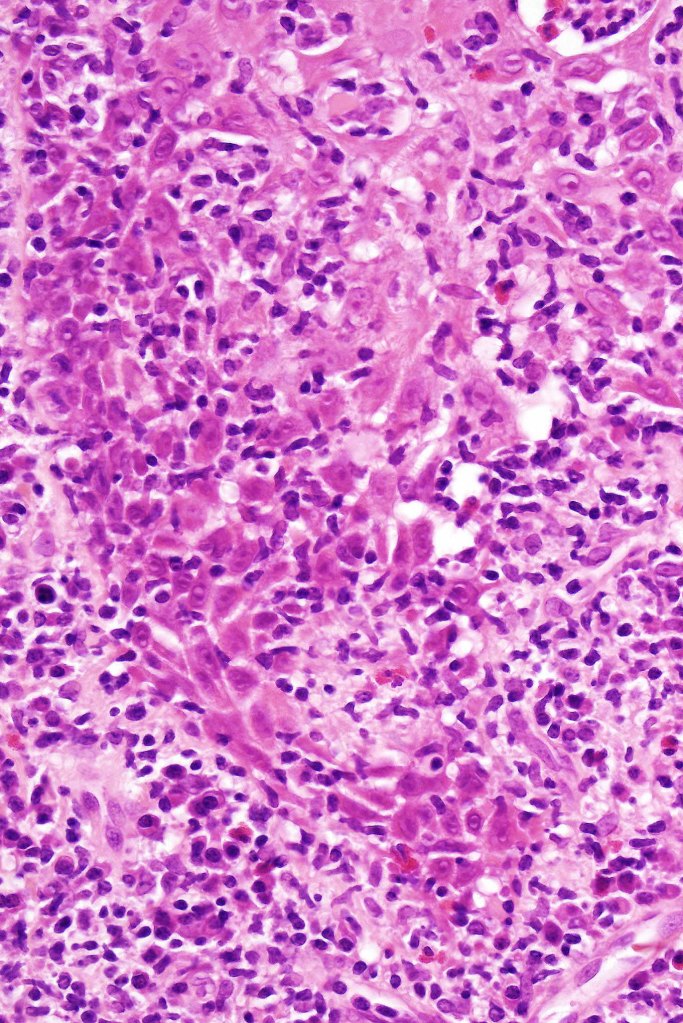
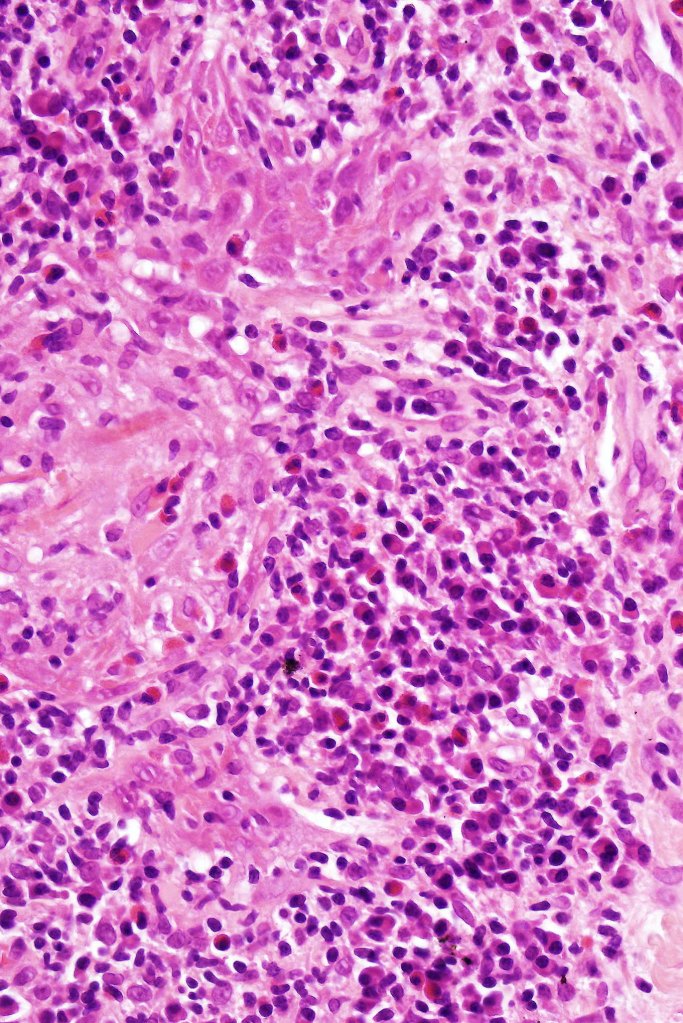
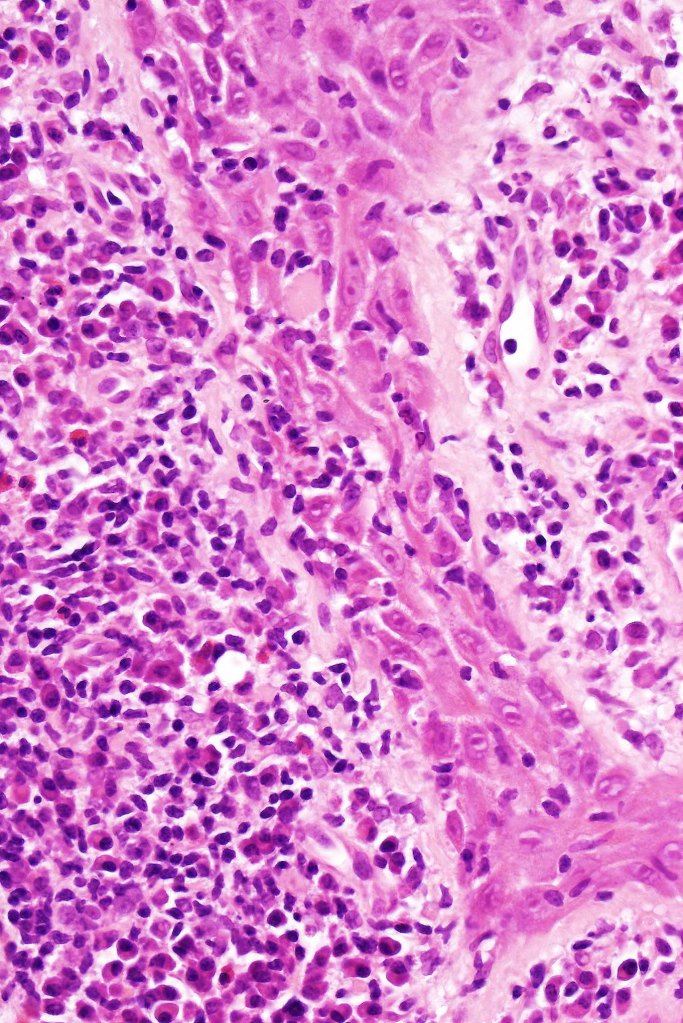

Clinical features
•May present with & without follicular mucinosis
•May be accompanied (and often is) by syringotropic MF
•Very rare & presents most commonly in middle-aged or elderly males
•Face, scalp (often associated with alopecia) & neck, trunk or limbs
•Eyebrow involvement is said to be typical
•Intensely itchy, patches, plaques or grouped papules
•Sometimes seen in tumor stage disease
•Occasionally acneiform & follicular keratosis-like lesions
•Difficult to treat because of depth of the lesions & associated with a poor prognosis
•Independent risk factor for progression



Histological features
•Epidermal involvement often absent
•Follicular infiltration by atypical lymphocytes & Sézary cells
•+/- mucinosis
•+/- syringotropic lesions
•+/- basaloid follicular hyperplasia
•Eosinophils sometimes conspicuous (eosinophilic folliculitis-like appearance)
•Granulomatous inflammation secondary to follicular destruction
•Large cell transformation occasionally present

Leave a comment